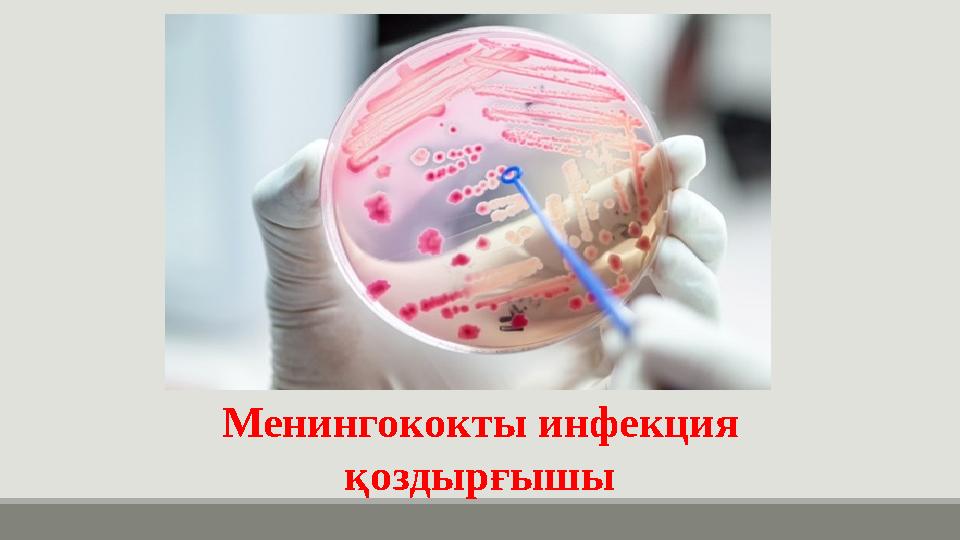
img_page_1

Менингококты инфекция қоздырғышы
Менингококты инфекция қоздырғышы
#1 слайд
Менингококты инфекция
қоздырғышы
1 слайд
Менингококты инфекция қоздырғышы
#2 слайд
Менингит - ми мен
жұлынның жұмсақ
қабықтарының қабынуы.
1887ж А.Вейксельбаум
науқас адамның жұлын
сұйықтығынан тапқан.
Менингиттің
қоздырғышы тыныс алу,
жөтелу кезінде ауа
арқылы таралады.
2 слайд
Менингит - ми мен жұлынның жұмсақ қабықтарының қабынуы. 1887ж А.Вейксельбаум науқас адамның жұлын сұйықтығынан тапқан. Менингиттің қоздырғышы тыныс алу, жөтелу кезінде ауа арқылы таралады.
#3 слайд
Менингококтар – ұсақ диплококтар. Ерекшелігі бір-біріне ойыс кофе дәні тәрізді
жұпты түрде орналасады. Менингококктар қозғалмайды,спора түзбейді, грам теріс,
капсуласы тұрақсыз, пилиі бар.
3 слайд
Менингококтар – ұсақ диплококтар. Ерекшелігі бір-біріне ойыс кофе дәні тәрізді жұпты түрде орналасады. Менингококктар қозғалмайды,спора түзбейді, грам теріс, капсуласы тұрақсыз, пилиі бар.
#4 слайд
Дақылдық өсіру
Аэробтарды құрамында қалыпты сарысуы бар қой немесе жылқының
дефибринделген ортасында,сонымен қатар ристомицин қосылған селективті
ортада өсіреді. СО2 концентрациясының жоғарылығы менингококтың өсуіне
ықпал етеді.
4 слайд
Дақылдық өсіру Аэробтарды құрамында қалыпты сарысуы бар қой немесе жылқының дефибринделген ортасында,сонымен қатар ристомицин қосылған селективті ортада өсіреді. СО2 концентрациясының жоғарылығы менингококтың өсуіне ықпал етеді.
#5 слайд
Резистенттілігі
Менингококтар қоршаған ортада тұрақсыз,кептіру мен суыққа
сезімтал болып келеді. 50 С-тан жоғары және 22 С төмен
температурада бірнеше минутта жойылып кетеді; пентциллинге,
тетрациклинге, эритромицинге сезімтал; ристомицинге және
сульфанидамидтерге тұрақты; 1% фенол ерітіндісіне, 0,2%
хлорлы әкке, 1% хлорамин ерітіндісіне сезімтал болып келеді.
5 слайд
Резистенттілігі Менингококтар қоршаған ортада тұрақсыз,кептіру мен суыққа сезімтал болып келеді. 50 С-тан жоғары және 22 С төмен температурада бірнеше минутта жойылып кетеді; пентциллинге, тетрациклинге, эритромицинге сезімтал; ристомицинге және сульфанидамидтерге тұрақты; 1% фенол ерітіндісіне, 0,2% хлорлы әкке, 1% хлорамин ерітіндісіне сезімтал болып келеді.
#6 слайд
Белгілері
Жоғары температура;
Бастың қатты ауыруы;
Жүректің айнуы және құсу
Мойынның шалқаюы. Баланың өңі кірмейді, сұлық жата береді, басы мен мойынын
артқа шалқайтып ұстайды.
Бір жасқа дейінгі баланың еңбегі көтеріледі (томпайып кетеді);
Кішкентай балаларда менингиттің алғашқы кезеңінде анықтау қиын. Бала түсініксіз
жағдайда, тіпті анасы емізгенде де жылай береді («менингит жылауы») немесе бала
ұйықтай береді;
6 слайд
Белгілері Жоғары температура; Бастың қатты ауыруы; Жүректің айнуы және құсу Мойынның шалқаюы. Баланың өңі кірмейді, сұлық жата береді, басы мен мойынын артқа шалқайтып ұстайды. Бір жасқа дейінгі баланың еңбегі көтеріледі (томпайып кетеді); Кішкентай балаларда менингиттің алғашқы кезеңінде анықтау қиын. Бала түсініксіз жағдайда, тіпті анасы емізгенде де жылай береді («менингит жылауы») немесе бала ұйықтай береді;
#7 слайд
Менингитің себептері:
-Химиялық заттектер
-дәрілік аллергия
-зеңдер
-Паразиттер
-Ісіктер.
Вирустық менингиттің көпшілігі
энтеровирустан болады, бұл
ішектің зақымдану себебі де
болуы мүмкін.
7 слайд
Менингитің себептері: -Химиялық заттектер -дәрілік аллергия -зеңдер -Паразиттер -Ісіктер. Вирустық менингиттің көпшілігі энтеровирустан болады, бұл ішектің зақымдану себебі де болуы мүмкін.
#8 слайд
Асқынулары
-Мидың зақымдануы
-Бассүйек пен мидың арасында сұйықтық
жиналуы (субдуралдық бөлініс)
-Құлақтың , көздің нашарлауы
-Гидроцефалия
-Құрысу
8 слайд
Асқынулары -Мидың зақымдануы -Бассүйек пен мидың арасында сұйықтық жиналуы (субдуралдық бөлініс) -Құлақтың , көздің нашарлауы -Гидроцефалия -Құрысу
#9 слайд
-қан
-жұлын сұйықтығы
мұрын қуысының шырышын зерттейді.
-Ми жұлын сұйықтығының центрифугаланған тұнбасын және араннан алынған
жағындыны микроскопиялық зерттегенде нейтрофилдың ішінде немесе жасушадан
тыс өзіне тән нейссериялар көрінеді.
Зертханалық диагностика
9 слайд
-қан -жұлын сұйықтығы мұрын қуысының шырышын зерттейді. -Ми жұлын сұйықтығының центрифугаланған тұнбасын және араннан алынған жағындыны микроскопиялық зерттегенде нейтрофилдың ішінде немесе жасушадан тыс өзіне тән нейссериялар көрінеді. Зертханалық диагностика
#10 слайд
Қосымша зерттеу әдістері де жүргізіледі:
-Кеуде қуысы ағзаларының шолу рентгенографиясы
-Мидың компьютерлік томографиясы (КТ).
10 слайд
Қосымша зерттеу әдістері де жүргізіледі: -Кеуде қуысы ағзаларының шолу рентгенографиясы -Мидың компьютерлік томографиясы (КТ).
#11 слайд
Дәрігер келгенге дейін:
әр 4 сағат сайын 500 мг апмициллин
салыңыз. Немесе әр 4 сағат сайын 1
млн ед. панициллин кристаллын
салыңыз.
Ыстығы жоғары болған жағдайда
(40°-тан астам) оны ылғал
компресспен бас
Этиотропты терапия пенициллин,
левомицетин, рифампицин
антибиотиктері қолданады.
Емдеу
11 слайд
Дәрігер келгенге дейін: әр 4 сағат сайын 500 мг апмициллин салыңыз. Немесе әр 4 сағат сайын 1 млн ед. панициллин кристаллын салыңыз. Ыстығы жоғары болған жағдайда (40°-тан астам) оны ылғал компресспен бас Этиотропты терапия пенициллин, левомицетин, рифампицин антибиотиктері қолданады. Емдеу
#12 слайд
Алдын алу
•Клиникалық көрінісін білген жағдайда тез арада емханаға
апару керек
•Антигемофильдік вакцина (вакцина ХИБ) балалардағы
бактериалдық менингиттің сәйкес түрінің алдын алуға
көмектеседі.
•Санитарлық шаралар өткізу.
•Менингитпен ауырған адам мен қатынаста болған
адамдарды оңашалап тексеру.
12 слайд
Алдын алу •Клиникалық көрінісін білген жағдайда тез арада емханаға апару керек •Антигемофильдік вакцина (вакцина ХИБ) балалардағы бактериалдық менингиттің сәйкес түрінің алдын алуға көмектеседі. •Санитарлық шаралар өткізу. •Менингитпен ауырған адам мен қатынаста болған адамдарды оңашалап тексеру.
#13 слайд
Баланы үй жағдайында тексеру әдістері
13 слайд
Баланы үй жағдайында тексеру әдістері
#14 слайд
14 слайд
#15 слайд
Фортуна
15 слайд
Фортуна
#16 слайд
Сәйкестендіру жауаптары
16 слайд
Сәйкестендіру жауаптары
шағым қалдыра аласыз













